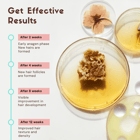
... ...

Experience the power of nature with our 100% natural Ayurvedic hair growth serum, enriched with blackseed oil, rosemary oil, virgin coconut oil, alkanet root, and almond oil. This potent serum is formulated to stop hair loss, promote hair growt...
Read MoreCoco Crush Pack of Hair Growth Serum & Leave-in Hair Repair Treatment Serum with Rosemary Oil | 100% Natural | Pack of 2 - 30ml each
Key Attributes
| Country of origin | India |
|---|---|
| Net Quantity | 2 units |
| Product Dimensions | 10L x 9W x 15H cm |
| Manufacturer or packer name | Sea Breeze |
Experience the power of nature with our 100% natural Ayurvedic hair growth serum, enriched with blackseed oil, rosemary oil, virgin coconut oil, alkanet root, and almond oil. This potent serum is formulated to stop hair loss, promote hair growth, and increase the volume of your hair, naturally.
Our serum is made using ancient Ayurvedic principles, combined with modern scientific research, to create a unique formula that nourishes and strengthens your hair from root to tip. Our ingredients are carefully sourced and combined in precise proportions to ensure maximum effectiveness.
| Country of origin | India |
|---|---|
| Common name | hair serums |
| Net Quantity | 2 units |
| Weight | 400 g |
| Package Dimension | 10L x 9W x 15H cm |
| Product Dimensions | 10L x 9W x 15H cm |
| Manufacturer or packer name | Sea Breeze |
| Manufacturer or packer address | C-8, Vasant Kunj New Delhi- 110098 |
| Manufacturing Date | Jun-23 |
| contact details consumer care | SEA BREEZE, [email protected] |